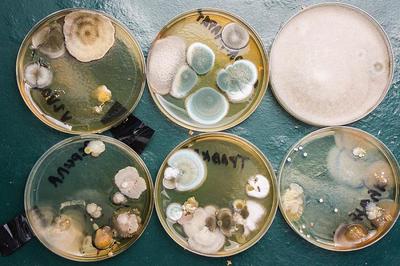
����������� � �����������

Как будет выглядеть апокалипсис
UPD: #comment_152780857
Вы думаете что апокалипсис начнется с яркого, послегрозового вкуса высоких радиационных полей? Металлического привкуса стронция и циркония? Сладковатого привкуса плутония? Неа. Все будет не так.
Апокалипсис будет выглядеть сухо, и строго. Вот так. К примеру.
Что это бумажка показывает не знаете? Нет? Ну я вкратце - это тест посева на антибиотики. Причем не чего либо - а синегнойной палочки, которая шутить не любит и действует КРАЙНЕ быстро. Что мы видим на данном листке? Полную нечуствительность к антибиотикам. Ага.
Комментарий к фото от врача, это перевод с английского
"Женщине, которая жалуется, потому что я не прописываю антибиотики ее ребенку, больному гриппом. Пациенту, который бросается в истерику, потому что у него болит горло и он хочет, чтобы я оставил ему азитромицин.
Людям, которые принимают амоксициллин от головной боли.
Тем, кто настаивает на том, что от лихорадки лучше всего использовать бензетацил, потому что он излечивает все инфекции и убивает всех возбудителей.
Другу, который принял только половину курса лечения, потому что он захотел выпить в конце недели и потому, что теперь его бактерии адаптировались и приспособились ко всем видам антибиотиков, и все из-за благословенной привычки говорить: "этот врач ничего не знает, с антибиотиками я вылечусь быстрее".
Вам, дамы и господа - бактерии, устойчивые ко всем антибиотикам."
Для понимания - на фото результат посева мочи на чувствительность к антибиотикам, из которого следует, что имеется инфекция - синегнойная палочка, которая у данного пациента устойчива ко всем антибиотикам и лечить больше нечем.
Финита ля комедия. И пациентке тоже.

Все о медицине
14.1K поста41.6K подписчиков
Правила сообщества
1)Не оскорбляйте друг друга
2) Ув. коллеги, при возникновении спора относитесь с уважением
3) спрашивая совета и рекомендации готовьтесь к тому что вы получите критику в свой адрес (интернет, пикабу в частности, не является медицинским сайтом).